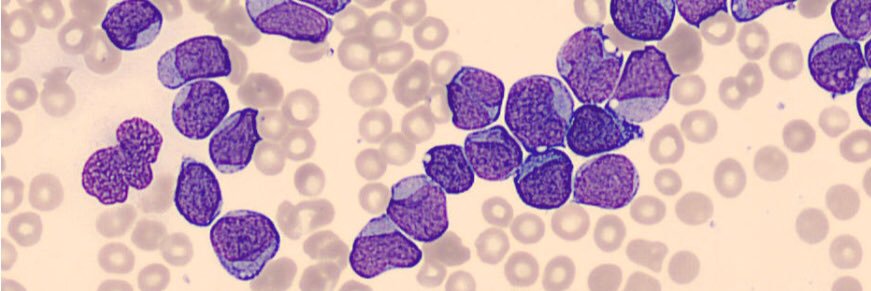
Alex Bataller banner

Alex Bataller retweetledi

👏Important new paper from our group led by .@TapKadia & @AlexBataller 👉just out in @AjHematology | #Cladribine #leusm #endcancer | @sanamloghavi
onlinelibrary.wiley.com/doi/epdf/10.10…

English
Alex Bataller
742 posts

@AlexBataller
MD PhD. Assistant Professor #Leukemia @MDAndersonNews, Houston (TX). From Barcelona | @hematoclinicbcn. Ski and mountains. I hate all types of cheese.
































7 children developed blood cancer after Bluebird Bio $BLUE gene therapy statnews.com/2024/10/09/blu… via @Jasonmmast